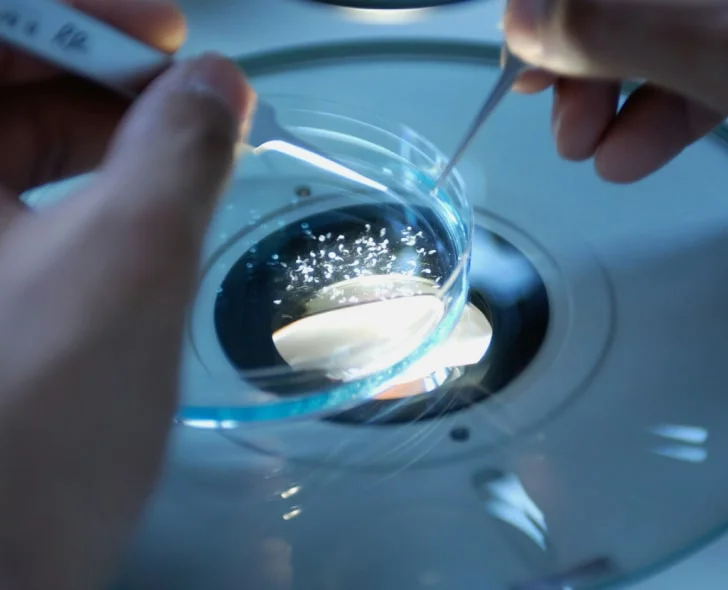

Costco Hearing Aid Center
- Free Hearing TestINCLUDED
Free Service Appointments†INCLUDED
FSA and HSA Eligible- Premium Technology
Up to 4% in Rewards*
Hearing aids accessories enhance overall performance by allowing users to stream phone calls and TV audio directly to their devices. Additionally, these accessories improve communication in social settings by focusing on the speaker’s voice, making everyday activities more engaging.
Types of Hearing Aid Accessories




For more information on hearing aid accessories or to learn about other products compatible with your hearing aids, call or visit any of our Costco Hearing Aid Centers. Find the Costco Hearing Aid Center near you.








Hearing Aid Battery Information

Battery packaging must meet Reese's Law legal requirements to enhance child safety standards for button batteries. The law requires manufacturers to implement stronger safeguards and the use of scissors to open the packaging to prevent exposure to swallowing hazards.










Hearing loss can be a challenging reality, not only for those who experience it but also for their loved ones and friends. Its impact extends far beyond a worsened ability to hear.
Science has shown that hearing loss can lead to social isolation, loneliness and depression. As well as physical issues with balance, and cognitive decline — even a greater risk of dementia.
By the Numbers

- Overall Health and Wellbeing: Taking control of your hearing can positively impact your health and overall quality of life.
- Good Brain Health: Hearing aids have been shown to support better brain health and may reduce cognitive decline.
- Less Loneliness: A well-managed hearing loss enables people to reconnect with family, friends, and colleagues.
- Better Mental Health: By breaking the cycle of isolation, hearing care directly contributes to improved mental health. quality of life.
- More Productivity: Having a hearing loss addressed can often benefit people’s professional life and productivity.
Frequently Asked Questions
Self-Evaluation
- You frequently turn up the volume on your TV, tablet, or phone.
- You have difficulty hearing conversations, particularly in noisy environments.
- You often ask people to repeat themselves, or you rely on someone close to you to repeat what others say.
- You study people's faces as they're talking, so you can fill in the gaps by reading their lips or expressions.
- You often have trouble understanding the person at the other end of the phone.
- You find yourself participating less in conversations, even with family and friends.
- You have difficulty hearing high-pitched sounds, like doorbells, devices beeping, or children's voices.
Contact the nearest Costco Hearing Aid Center to schedule a hearing test appointment. Please print and complete a Hearing Aid Member Intake Form, and bring it in with you to your appointment.
The length of time it takes to adapt to hearing aids will depend on how quickly you address your hearing loss. Research shows that most people can adjust to hearing aids within 30 days, with regular use. That’s why it’s important to wear your hearing aids daily, so you can adapt more quickly and more completely. Be patient during the adjustment period. Remember that some sounds will be different, and you may need to adjust the volume level. Costco providers can program your hearing aids to gradually increase the amplification over a customized period of time, to help you adjust to hearing sounds that you may not have heard for a long time. If you have questions or concerns, don’t hesitate to contact your local Costco Hearing Aid Center.





